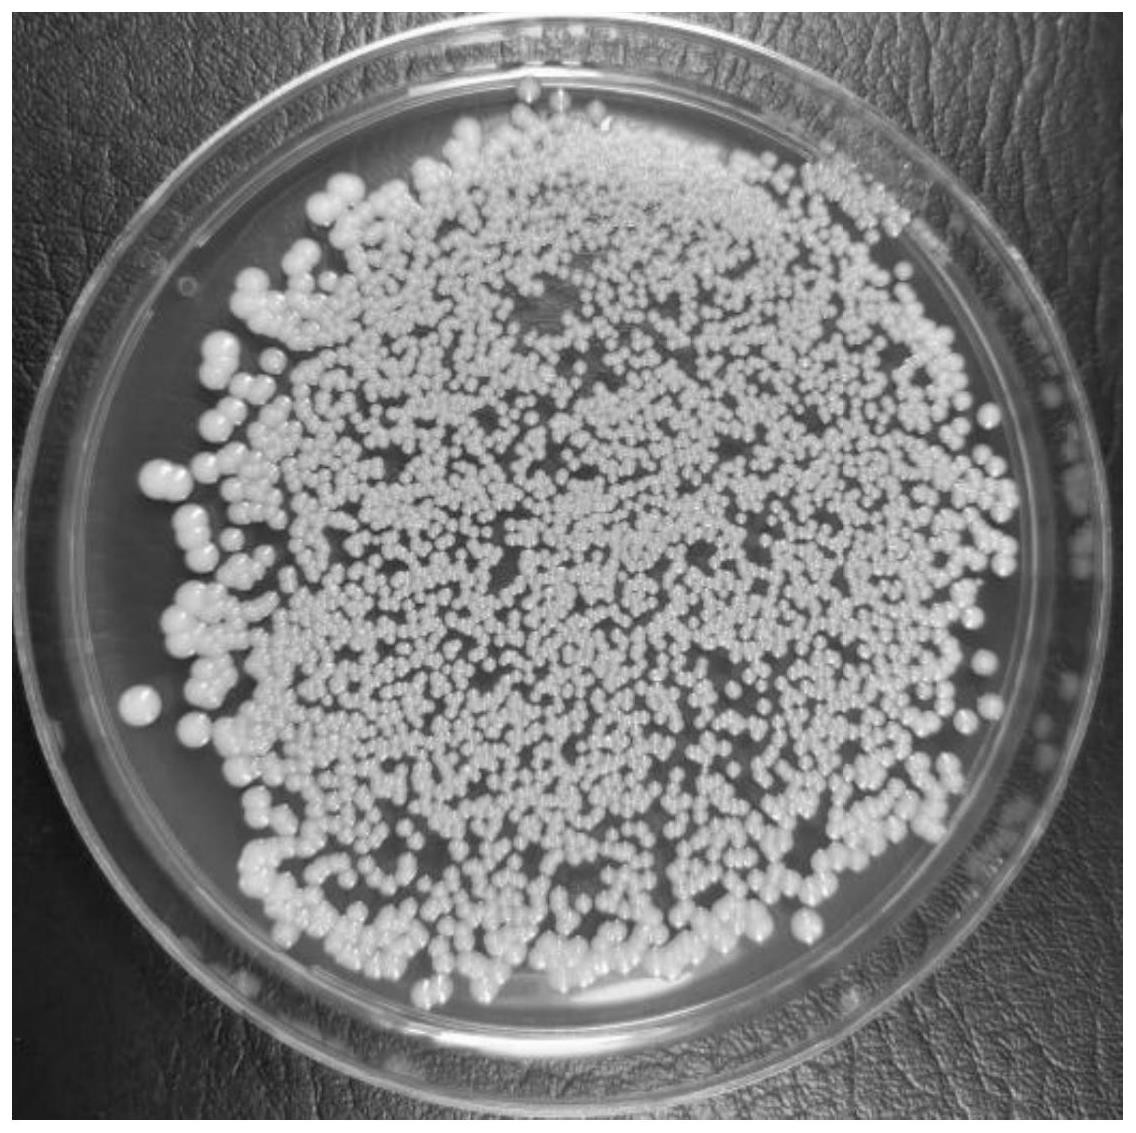

授权公布号:CN115197858B
一种高产乙酸乙酯费比恩毕赤酵母在清香型小曲白酒中的应用
有效
申请
2022-08-02
申请公布
2022-10-18
授权
2023-05-05
预估到期
2042-08-02
| 申请号 | CN202210920335.X |
| 申请日 | 2022-08-02 |
| 申请公布号 | CN115197858A |
| 申请公布日 | 2022-10-18 |
| 授权公布号 | CN115197858B |
| 授权公告日 | 2023-05-05 |
| 分类号 | C12N1/16;C12G3/021;C12R1/84N |
| 分类 | 生物化学;啤酒;烈性酒;果汁酒;醋;微生物学;酶学;突变或遗传工程; |
| 申请人名称 | 劲牌有限公司 |
| 申请人地址 | 湖北省黄石市大冶市大冶大道169号 |
专利法律状态
2023-05-05
授权
状态信息
授权
2022-10-18
公布
状态信息
公布
摘要
本发明公开了一种高产乙酸乙酯费比恩毕赤酵母及其在清香型小曲白酒生产中的应用。所述费比恩毕赤酵母菌株为费比恩毕赤酵母(Pichia fabianii)Y10菌株,保藏于中国典型培养物保藏中心(CCTCC),保藏日期为2022年4月29日,保藏编号为CCTCC NO:M2022527。本发明的高产酯费比恩毕赤酵母具有良好的温度、高糖、低酸和酒精耐受性,能够适应清香型小曲白酒发酵酿造环境要求。将该酵母制备的酒曲与桂花曲配成混合曲应用于清香型小曲原酒酿造中,生产出的酒体中乙酸乙酯含量达1.07g/L,比生产对照组提升了55%。